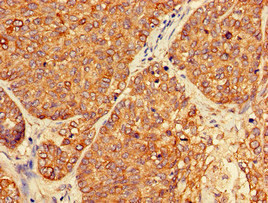

PER3 Antibody
-
中文名稱:PER3兔多克隆抗體
-
貨號:CSB-PA017788LA01HU
-
規格:¥440
-
圖片:
-
Western Blot
Positive WB detected in: Hela whole cell lysate, Mouse skeletal muscle tissue
All lanes: PER3 antibody at 4µg/ml
Secondary
Goat polyclonal to rabbit IgG at 1/50000 dilution
Predicted band size: 132, 133 kDa
Observed band size: 132 kDa -
Immunohistochemistry of paraffin-embedded human ovarian cancer using CSB-PA017788LA01HU at dilution of 1:100
-
Immunohistochemistry of paraffin-embedded human colon cancer using CSB-PA017788LA01HU at dilution of 1:100
-
Immunofluorescent analysis of Hela cells using CSB-PA017788LA01HU at dilution of 1:100 and Alexa Fluor 488-congugated AffiniPure Goat Anti-Rabbit IgG(H+L)
-
-
其他:
產品詳情
-
產品描述:
The PER3 polyclonal antibody is generated in rabbits by injecting them with a recombinant protein that corresponds to amino acids 1-131 of the human PER3 protein. Following inoculation, the rabbits' sera are purified using protein G affinity chromatography, yielding the PER3 antibody with a purity level of over 95%. The PER3 antibody is supplied in a buffer containing stabilizers as a liquid solution. Its specificity and sensitivity have been confirmed for human and mouse PER3 proteins using four applications, including ELISA, WB, IF, and IHC.
PER3 protein acts as a negative regulator of the circadian clock and helps regulate the duration of the circadian period. It plays an important role in regulating sleep-wake cycles, hormone secretion, metabolism, and other physiological processes. Variations in the PER3 gene can lead to differences in circadian rhythm, sleep timing, and susceptibility to circadian rhythm disorders and certain types of cancer.
-
產品名稱:Rabbit anti-Homo sapiens (Human) PER3 Polyclonal antibody
-
Uniprot No.:
-
基因名:PER3
-
別名:2810049O06Rik antibody; Cell growth inhibiting gene 13 protein antibody; Cell growth-inhibiting gene 13 protein antibody; Circadian clock protein PERIOD 3 antibody; GIG13 antibody; gPER3 antibody; Growth inhibiting protein 13 antibody; HGNC:8847 antibody; hPER3 antibody; mPer3 antibody; Per3 antibody; PER3_HUMAN antibody; Period 3 antibody; Period circadian clock 3 antibody; Period circadian protein 3 antibody; Period circadian protein homolog 3 antibody; Period homolog 3 (Drosophila) antibody; Period homolog 3 antibody; Period homolog 3; Drosophila antibody; Period3 antibody
-
宿主:Rabbit
-
反應種屬:Human, Mouse
-
免疫原:Recombinant Human Period circadian protein homolog 3 protein (1-131AA)
-
免疫原種屬:Homo sapiens (Human)
-
標記方式:Non-conjugated
本頁面中的產品,PER3 Antibody (CSB-PA017788LA01HU),的標記方式是Non-conjugated。對于PER3 Antibody,我們還提供其他標記。見下表:
-
克隆類型:Polyclonal
-
抗體亞型:IgG
-
純化方式:>95%, Protein G purified
-
濃度:It differs from different batches. Please contact us to confirm it.
-
保存緩沖液:Preservative: 0.03% Proclin 300
Constituents: 50% Glycerol, 0.01M PBS, pH 7.4 -
產品提供形式:Liquid
-
應用范圍:ELISA, WB, IHC, IF
-
推薦稀釋比:
Application Recommended Dilution WB 1:500-1:5000 IHC 1:20-1:200 IF 1:50-1:200 -
Protocols:
-
儲存條件:Upon receipt, store at -20°C or -80°C. Avoid repeated freeze.
-
貨期:Basically, we can dispatch the products out in 1-3 working days after receiving your orders. Delivery time maybe differs from different purchasing way or location, please kindly consult your local distributors for specific delivery time.
-
用途:For Research Use Only. Not for use in diagnostic or therapeutic procedures.
相關產品
靶點詳情
-
功能:Originally described as a core component of the circadian clock. The circadian clock, an internal time-keeping system, regulates various physiological processes through the generation of approximately 24 hour circadian rhythms in gene expression, which are translated into rhythms in metabolism and behavior. It is derived from the Latin roots 'circa' (about) and 'diem' (day) and acts as an important regulator of a wide array of physiological functions including metabolism, sleep, body temperature, blood pressure, endocrine, immune, cardiovascular, and renal function. Consists of two major components: the central clock, residing in the suprachiasmatic nucleus (SCN) of the brain, and the peripheral clocks that are present in nearly every tissue and organ system. Both the central and peripheral clocks can be reset by environmental cues, also known as Zeitgebers (German for 'timegivers'). The predominant Zeitgeber for the central clock is light, which is sensed by retina and signals directly to the SCN. The central clock entrains the peripheral clocks through neuronal and hormonal signals, body temperature and feeding-related cues, aligning all clocks with the external light/dark cycle. Circadian rhythms allow an organism to achieve temporal homeostasis with its environment at the molecular level by regulating gene expression to create a peak of protein expression once every 24 hours to control when a particular physiological process is most active with respect to the solar day. Transcription and translation of core clock components (CLOCK, NPAS2, ARNTL/BMAL1, ARNTL2/BMAL2, PER1, PER2, PER3, CRY1 and CRY2) plays a critical role in rhythm generation, whereas delays imposed by post-translational modifications (PTMs) are important for determining the period (tau) of the rhythms (tau refers to the period of a rhythm and is the length, in time, of one complete cycle). A diurnal rhythm is synchronized with the day/night cycle, while the ultradian and infradian rhythms have a period shorter and longer than 24 hours, respectively. Disruptions in the circadian rhythms contribute to the pathology of cardiovascular diseases, cancer, metabolic syndromes and aging. A transcription/translation feedback loop (TTFL) forms the core of the molecular circadian clock mechanism. Transcription factors, CLOCK or NPAS2 and ARNTL/BMAL1 or ARNTL2/BMAL2, form the positive limb of the feedback loop, act in the form of a heterodimer and activate the transcription of core clock genes and clock-controlled genes (involved in key metabolic processes), harboring E-box elements (5'-CACGTG-3') within their promoters. The core clock genes: PER1/2/3 and CRY1/2 which are transcriptional repressors form the negative limb of the feedback loop and interact with the CLOCK|NPAS2-ARNTL/BMAL1|ARNTL2/BMAL2 heterodimer inhibiting its activity and thereby negatively regulating their own expression. This heterodimer also activates nuclear receptors NR1D1, NR1D2, RORA, RORB and RORG, which form a second feedback loop and which activate and repress ARNTL/BMAL1 transcription, respectively. Has a redundant role with the other PER proteins PER1 and PER2 and is not essential for the circadian rhythms maintenance. In contrast, plays an important role in sleep-wake timing and sleep homeostasis probably through the transcriptional regulation of sleep homeostasis-related genes, without influencing circadian parameters. Can bind heme.
-
基因功能參考文獻:
- Study identified several CpG sites and specifically several CpGs in the PTPRS and PER3 genes differentially methylated between obese and non-obese children, suggesting a role for DNA methylation concerning development of childhood obesity. PMID: 28614626
- these findings suggest that rhythmic expression of the circadian clock gene PER3 is associated with the amount of daily physical activity and physical fitness in older adults PMID: 28045078
- PER3 polymorphisms links with chronotype and affective dimensions PMID: 28708003
- data suggest that, PER3(4/4) genotype may accelerate the course of disease in multiple sclerosis susceptible individuals especially in women PMID: 29055480
- The impact of PER3 polymorphisms on sleep cycle and insomnia in older adults is reported. PMID: 28276850
- there is a significant association between the PER3 polymorphism and the extraversion personality trait PMID: 28055273
- PER34/4 genotype may accelerate the course of disease in multiple sclerosis susceptible individuals. PMID: 29055479
- CLOCK rs1801260*C and PER3(4/4) influence myelination processes by regulating sleep quality and quantity. PMID: 27996307
- 4 and 5 variable-number tandem-repeat polymorphisms appear to influence sensitivity to the effects of stressful urban environments on sleep PMID: 27593530
- Data suggest that three E box-like response elements are located upstream of PER3 transcription start sites; these response elements appear to additively contribute to cell-autonomous transcriptional oscillation of PER3 and other circadian proteins. PMID: 28821614
- This study showed that Lack of Association between Genetic Polymorphism of PER3 gene with Late Onset Depression and Alzheimer's Disease in a Sample of a Brazilian Population PMID: 27335043
- This study shown a possible association between Per3 polymorphism and consciousness recovery level in Disorders of Consciousness patients. PMID: 26359345
- PER3 variants may be associated with decreased risk for depressive symptoms, including subthreshold levels of depressive symptoms, in older adults. PMID: 25892098
- The PER1 c.2884C > G polymorphism and PER3 54bp VNTR were associated with annual percent changes in bone mineral density of femoral neck after 1 year of hormone therapy. PMID: 26624862
- PER3 polymorphism is associated with sleep quality after a mild traumatic brain injury. PMID: 26440425
- PER3 VNTR polymorphism influences both response to antidepressant chronotherapeutics and total sleep time after the repeated sleep deprivation treatment in patients with bipolar depression. PMID: 26707349
- No association between cluster headache, PER3 VNTR polymorphism and chronotype was found in this study. PMID: 26922944
- There was no significant association between the PER3 VNTR polymorphism and the irregularity of the menstrual cycle in Korean adolescents. PMID: 26453284
- A role for PER3 in modulating circadian clock and mood during seasonal changes PMID: 26903630
- This work suggests a role of PER3 rs10462020 in predicting a prognosis in Diffuse large B-cell lymphoma overall survival of patients. PMID: 26406960
- evidence of an association between PER3 gene and planning performance in a sample of healthy subjects PMID: 25798540
- PER3 VNTR genotype does not explain the difference in chronotype between South African and Dutch marathon runners PMID: 26102236
- minor polymorphisms of PER3 may be associated with poor morning gastric motility, and may have a combinatorial effect with CLOCK. PMID: 25775462
- The findings support the notion that PER3 polymorphisms could be a potential genetic marker for an individual's circadian and sleep phenotypes. PMID: 25201053
- PER3 long allele carriers were more vulnerable to sleep-loss associated attentional lapses than those with the short allele. PMID: 25940842
- length polymorphism in the Period 3 gene is associated with sleepiness and maladaptive circadian phase in night-shift workers PMID: 25545397
- In patients with non-small cell lung cancer, those with lower expression of Per1, Per2 and Per3 had a shorter survival time than those with higher expression. PMID: 25550826
- PERIOD3 clock gene length polymorphism may have a role in colorectal adenoma formation PMID: 25501848
- The data indicate that humans homozygous for the PER3(5/5) allele are more sensitive to NIF light effects, as indexed by specific changes in sleep EEG activity. PMID: 24893318
- no evidence supporting a global association of PER3 genetic variants with the incidence of cancer (Meta-Analysis) PMID: 25837749
- The polymorphisms studied in PER3 did not demonstrate any relationship with Bone Mineral Density or the odds of osteoporosis in postmenopausal Korean women. PMID: 24678593
- Provide some evidence that circadian rhythm of flight cadets with the PER3 (5) allele are less likely to be affected compared to those with the PER3 (4) allele. PMID: 25400784
- A wild genotype of rs228729 in PER3 was the primary risk factor contributing to Chinese hepatocellular carcinoma patients recurrence-free survival. PMID: 25344870
- An association is outlined of Per3 five repeat allele with T2DM occurrence and suggest that individuals with five repeat allele may be at a greater risk for T2DM as compared to those carrying the four repeat allele. PMID: 25390010
- PER3, at least partially, was targeted by miRNA-103, which might affect cells apoptosis in G2/M phase by modulating apoptosis-related gene in p53 pathway. PMID: 24393525
- Per3 VNTR may contribute to modulation of cardiac functions and interindividual differences in development and progression of myocardial infarction PMID: 24866331
- Per3 variable number tandem repeat polymorphism is not a major risk factor for chronic heart failure (CHF) or a factor modulating the severity of the CHF in this population. PMID: 23128810
- there is significant association between diurnal preference and a polymorphism in PER3 and a novel nominally significant association between diurnal preference and a polymorphism in ARNTL2 PMID: 24635757
- Five SNPs (rs228727, rs228644, rs228729, rs707467, rs104620202) in the period 3 (PER3) gene are significant correlation with genotype and allele frequency in lung cancer. PMID: 24821610
- No association with SNPs or haplotypes of the PER3 gene was observed in prophylactic lithium response. PMID: 24636202
- there is a greater detrimental impact of sleep deprivation in PER3(5/5) than PER3(4/4) carriers. the group with greater attentional performance impairment due to sleep deprivation (PER3(5/5) carriers) is superior at initiating sleep over the 24-h cycle. PMID: 24439663
- Women with the 4/5 or 5/5 PER3 genotype had a nonstatistically significant 33% increased odds of breast cancer. PMID: 24903750
- PER3 genotype predicted circadian rhythm period lengthening by lithium, specifically among bipolar disorder cases. PMID: 24150227
- the association of rs934945 with "morning alertness" and rs2640909 with "morningness". PMID: 23969301
- there is significant daily variation in PER2, PER3, and ARNTL1 expression with earlier timing of expression in women than in men PMID: 23606611
- polymorphisms more behaviorally salient with increasing severity and/or duration of sleep restriction PMID: 23171222
- These data document for the first time that the expression of BMAL1, PER3, PPARD and CRY2 genes is altered in gestational diabetes compared to normal pregnant women. deranged expression of clock genes may play a pathogenic role in GDM. PMID: 23323702
- Studies indicate that in the cytoplasm, PER3 protein heterodimerizes with PER1, PER2, CRY1, and CRY2 proteins and enters into the nucleus, resulting in repression of CLOCK-BMAL1-mediated transcription. PMID: 23546644
- Cortisol secretion was modified among police officers with different PER3 VNTR clock gene variants. PMID: 23524621
- the association study of the 54-nucleotide repeat in exon 18 of the hPer3 gene with a predisposition to opioid dependence among residents of the West Siberian region of Russia PMID: 22976125
顯示更多
收起更多
-
相關疾病:Advanced sleep phase syndrome, familial, 3 (FASPS3)
-
亞細胞定位:Cytoplasm. Nucleus.
-
數據庫鏈接:
Most popular with customers
-
-
Phospho-YAP1 (S127) Recombinant Monoclonal Antibody
Applications: ELISA, WB, IHC
Species Reactivity: Human
-
-
-
-
-
-